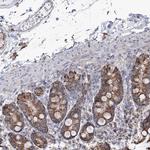
CWF19L1 Antibody in Immunohistochemistry (Paraffin) (IHC (P))

Search
Invitrogen
CWF19L1 Polyclonal Antibody
{{$productOrderCtrl.translations['antibody.pdp.commerceCard.promotion.promotions']}}
{{$productOrderCtrl.translations['antibody.pdp.commerceCard.promotion.viewpromo']}}
{{$productOrderCtrl.translations['antibody.pdp.commerceCard.promotion.promocode']}}: {{promo.promoCode}} {{promo.promoTitle}} {{promo.promoDescription}}. {{$productOrderCtrl.translations['antibody.pdp.commerceCard.promotion.learnmore']}}

Please note: We are reviewing Western blot images included in the antibody testing data in our catalog, including those provided by third parties. Unless expressly labeled or annotated as “raw-unedited”, Western blot images included in the antibody testing data in our catalog may have been edited, optimized or otherwise adjusted for presentation.
产品信息
PA5-57859
种属反应
宿主/亚型
分类
类型
抗原
偶联物
形式
浓度
规格
纯化类型
保存液
内含物
保存条件
运输条件
RRID
产品详细信息
Immunogen sequence: KDVSSLRMML CTTSQFKGVD ILLTSPWPKC VGNFGNSSGE VDTKKCGSAL VSSLATGLKP RYHFAALEKT YYERLPYRNH IILQENAQHA TRF
Highest antigen sequence identity to the following orthologs: Mouse - 86%, Rat - 85%.
靶标信息
CWF19L1 (CWF19 Like Cell Cycle Control Factor 1) is a gene located on chromosome 10 and encodes a protein involved in the regulation of mRNA splicing and cell cycle control. The protein interacts with key splicing factors within the nucleus, including components of the U5 small nuclear ribonucleoprotein (snRNP) and the pre-mRNA processing factor 19 (PRPF19) complex. CWF19L1 plays a crucial role in the alternative splicing of immune-related genes, thereby influencing the expression levels of cytotoxic molecules and enhancing T-cell cytotoxicity. Pathogenic variants in CWF19L1 have been linked to a rare autosomal recessive form of hereditary ataxia known as SCAR17 (Spinocerebellar Ataxia, Autosomal Recessive 17), characterized by symptoms such as global developmental delay, cerebellar ataxia, pyramidal signs, and seizures. This gene's deficiency disrupts normal mRNA splicing and leads to significant alterations in gene expression, impacting cellular and neurological functions.
仅用于科研。不用于诊断过程。未经明确授权不得转售。




